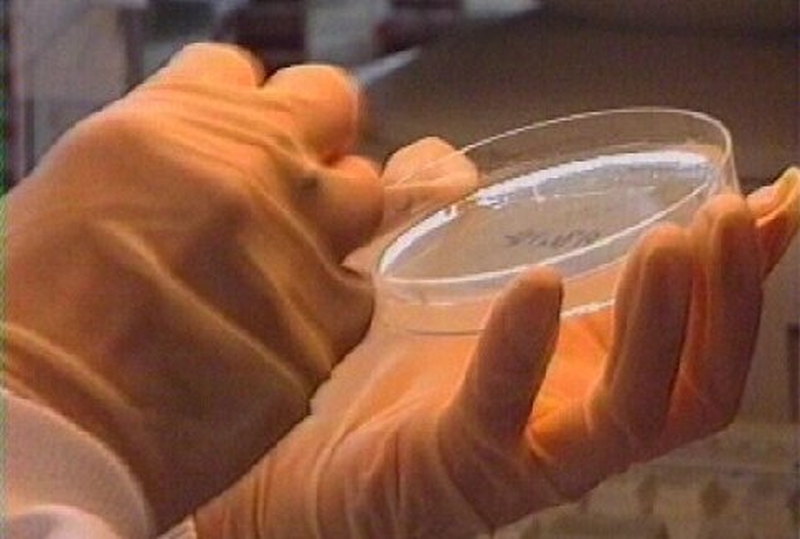
MRSA - Superbug prevalent, report says

The Irish Patients' Association has expressed alarm at the degree to which the superbug, MRSA, has become prevalent in hospitals.
The association said there is an onus on hospitals to reassure patients being admitted for treatment that the facilities were clean and good hygiene practices were being followed.
The association's chairman, Stephen McMahon, said the hospitals with the biggest problem had to be identified.
He was responding to a new report which found that the antibiotic-resistant superbug is prevalent in most hospitals in Ireland and has also been detected in nursing homes.
MRSA is a bacterium that can reside on the skin and is found in the nose of around one third of healthy individuals. Problems occur when it accesses deep tissue, for example through a surgical wound.
The Report on the Control of MRSA in Ireland calls for measures to prevent overcrowding in hospitals, to ensure sufficient space between beds, and better hygiene control.
Ireland has significantly higher levels than a number of EU countries for the bacterium, which kills between 20% to 50% of those infected in their blood stream.
The report recommends more isolation rooms for infected patients, better hand washing by health staff between patients, and more prudent use of antibiotics.
It says that hospital funding to control the spread of MRSA is below international standards, and that understaffing in hospitals is a factor.
Hospital chief executives should have corporate responsibility for the clean physical environment of the hospital, the report says.
MRSA became an officially notifiable disease this year.